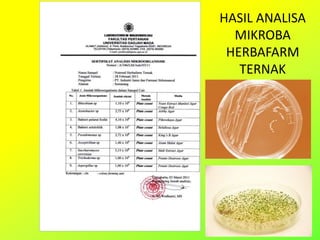
HASIL ANALISA
MIKROBA
HERBAFARM
TERNAK

Dokumen tersebut membahas tentang manfaat bakteri probiotik untuk meningkatkan hasil ternak dan tanaman melalui penggunaan pupuk organik dan mikroba tanah. Dibahas pula produk-produk pupuk organik seperti Herbafarm, Herbafarm Granular, dan Herbafarm Ternak yang mengandung unsur hara, mikroba, dan komposisi untuk meningkatkan pertumbuhan tanaman dan ternak.